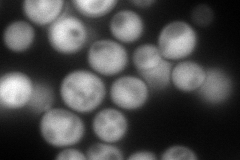
YER042W
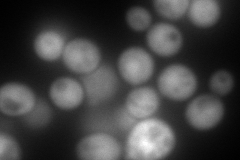
YER042W
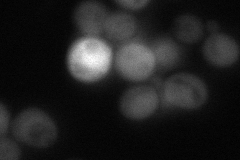
YER042W

View description
Methionine-S-sulfoxide reductase, involved in the response to oxidative stress; protects iron-sulfur clusters from oxidative inactivation along with MXR2; involved in the regulation of lifespan
Localization:
Intensity:
Fold change:
Significance:
-
C’ GFP library in SD

below threshold17.14 -
N' NOP1pr-GFP in SD
cytosol213.468 -
N' TEF2pr-mCherry in SD
cytosol319.341 -
N' NATIVEpr-GFP in SD
cytosol23.8512 -
N' TEF2pr-VC and Cyto-VN in SD

#N/A0 -
C’ GFP library in SD+DTT

cytosol14.830.86No -
C’ GFP library in SD+H2O2

cytosol15.270.89No -
C’ GFP library in Starvation Media

cytosol16.620.96No -
C’ GFP library on the background of Pup2-DaMP

below threshold -
C’ GFP library on the background of CCT mutant

below threshold17.55871.02387No
